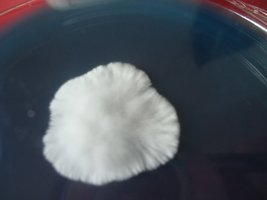

-
 cdd-pos001.jpg52 KB · Visualizações: 170
cdd-pos001.jpg52 KB · Visualizações: 170 -
 cdd-pos002.jpg90.4 KB · Visualizações: 165
cdd-pos002.jpg90.4 KB · Visualizações: 165 -
 cdd-pos003.jpg50.1 KB · Visualizações: 162
cdd-pos003.jpg50.1 KB · Visualizações: 162 -
 cdd-pos004.jpg55.8 KB · Visualizações: 167
cdd-pos004.jpg55.8 KB · Visualizações: 167 -
 cdd-pos005.jpg59.8 KB · Visualizações: 166
cdd-pos005.jpg59.8 KB · Visualizações: 166 -
 cdd-pos006.jpg59.8 KB · Visualizações: 171
cdd-pos006.jpg59.8 KB · Visualizações: 171 -
 cdd-pos007.jpg69.2 KB · Visualizações: 162
cdd-pos007.jpg69.2 KB · Visualizações: 162 -
 cdd-pos008.jpg78.7 KB · Visualizações: 159
cdd-pos008.jpg78.7 KB · Visualizações: 159 -
 cdd-pos009.jpg54.9 KB · Visualizações: 148
cdd-pos009.jpg54.9 KB · Visualizações: 148 -
 cdd-pos010.jpg64.2 KB · Visualizações: 152
cdd-pos010.jpg64.2 KB · Visualizações: 152 -
 cdd-pos011.jpg51 KB · Visualizações: 161
cdd-pos011.jpg51 KB · Visualizações: 161 -
 cdd-pos012.jpg45.2 KB · Visualizações: 156
cdd-pos012.jpg45.2 KB · Visualizações: 156 -
 cdd-pos013.jpg76.9 KB · Visualizações: 160
cdd-pos013.jpg76.9 KB · Visualizações: 160 -
 cdd-pos014.jpg69.9 KB · Visualizações: 164
cdd-pos014.jpg69.9 KB · Visualizações: 164 -
 cdd-pos015.jpg91.5 KB · Visualizações: 156
cdd-pos015.jpg91.5 KB · Visualizações: 156 -
 cdd-pos016.jpg72.2 KB · Visualizações: 163
cdd-pos016.jpg72.2 KB · Visualizações: 163 -
 cdd-pos017.jpg108 KB · Visualizações: 163
cdd-pos017.jpg108 KB · Visualizações: 163 -
 cdd-pos018.jpg74.4 KB · Visualizações: 165
cdd-pos018.jpg74.4 KB · Visualizações: 165 -
 cdd-pos019.jpg58.2 KB · Visualizações: 168
cdd-pos019.jpg58.2 KB · Visualizações: 168 -
 cdd-pos020.jpg85.2 KB · Visualizações: 150
cdd-pos020.jpg85.2 KB · Visualizações: 150 -
 cdd-pos021.jpg70.3 KB · Visualizações: 165
cdd-pos021.jpg70.3 KB · Visualizações: 165 -
 cdd-pos022.jpg68 KB · Visualizações: 158
cdd-pos022.jpg68 KB · Visualizações: 158 -
 cdd-pos023.jpg109.1 KB · Visualizações: 153
cdd-pos023.jpg109.1 KB · Visualizações: 153 -
 cdd-pos024.jpg98 KB · Visualizações: 171
cdd-pos024.jpg98 KB · Visualizações: 171 -
 cdd-pos025.jpg96.8 KB · Visualizações: 160
cdd-pos025.jpg96.8 KB · Visualizações: 160 -
 cdd-pos026.jpg98.9 KB · Visualizações: 151
cdd-pos026.jpg98.9 KB · Visualizações: 151 -
 cdd-pos027.jpg93.9 KB · Visualizações: 148
cdd-pos027.jpg93.9 KB · Visualizações: 148 -
 cdd-pos028.jpg89.4 KB · Visualizações: 151
cdd-pos028.jpg89.4 KB · Visualizações: 151 -
 cdd-pos029.jpg94.5 KB · Visualizações: 154
cdd-pos029.jpg94.5 KB · Visualizações: 154 -
 cdd-pos030.jpg83.1 KB · Visualizações: 150
cdd-pos030.jpg83.1 KB · Visualizações: 150 -
 cdd-pos031.jpg47.8 KB · Visualizações: 144
cdd-pos031.jpg47.8 KB · Visualizações: 144 -
 cdd-pos032.jpg47.2 KB · Visualizações: 161
cdd-pos032.jpg47.2 KB · Visualizações: 161 -
 cdd-pos033.jpg52.1 KB · Visualizações: 160
cdd-pos033.jpg52.1 KB · Visualizações: 160 -
 cdd-pos034.jpg43.7 KB · Visualizações: 146
cdd-pos034.jpg43.7 KB · Visualizações: 146 -
 cdd-pos035.jpg90.5 KB · Visualizações: 147
cdd-pos035.jpg90.5 KB · Visualizações: 147 -
 cdd-pos036.jpg86.2 KB · Visualizações: 148
cdd-pos036.jpg86.2 KB · Visualizações: 148 -
 cdd-pos037.jpg43.4 KB · Visualizações: 148
cdd-pos037.jpg43.4 KB · Visualizações: 148 -
 cdd-pos038.jpg43.2 KB · Visualizações: 147
cdd-pos038.jpg43.2 KB · Visualizações: 147 -
 cdd-pos039.jpg69.2 KB · Visualizações: 147
cdd-pos039.jpg69.2 KB · Visualizações: 147 -
 cdd-pos040.jpg83.5 KB · Visualizações: 148
cdd-pos040.jpg83.5 KB · Visualizações: 148 -
 cdd-pos041.jpg125.5 KB · Visualizações: 139
cdd-pos041.jpg125.5 KB · Visualizações: 139 -
 cdd-pos042.jpg63.8 KB · Visualizações: 140
cdd-pos042.jpg63.8 KB · Visualizações: 140 -
 cdd-pos043.jpg70.5 KB · Visualizações: 140
cdd-pos043.jpg70.5 KB · Visualizações: 140 -
 cdd-pos044.jpg52.4 KB · Visualizações: 138
cdd-pos044.jpg52.4 KB · Visualizações: 138 -
 cdd-pos045.jpg67.8 KB · Visualizações: 141
cdd-pos045.jpg67.8 KB · Visualizações: 141 -
 cdd-pos046.jpg42.7 KB · Visualizações: 135
cdd-pos046.jpg42.7 KB · Visualizações: 135 -
 cdd-pos047.jpg40.5 KB · Visualizações: 129
cdd-pos047.jpg40.5 KB · Visualizações: 129 -
 cdd-pos048.jpg47.4 KB · Visualizações: 126
cdd-pos048.jpg47.4 KB · Visualizações: 126 -
 cdd-pos049.jpg54.6 KB · Visualizações: 127
cdd-pos049.jpg54.6 KB · Visualizações: 127 -
 cdd-pos050.jpg43 KB · Visualizações: 127
cdd-pos050.jpg43 KB · Visualizações: 127 -
 cdd-pos051.jpg50.1 KB · Visualizações: 132
cdd-pos051.jpg50.1 KB · Visualizações: 132 -
 cdd-pos052.jpg50.9 KB · Visualizações: 123
cdd-pos052.jpg50.9 KB · Visualizações: 123 -
 cdd-pos053.jpg38.1 KB · Visualizações: 127
cdd-pos053.jpg38.1 KB · Visualizações: 127 -
 cdd-pos054.jpg48.7 KB · Visualizações: 125
cdd-pos054.jpg48.7 KB · Visualizações: 125 -
 cdd-pos055.jpg63.2 KB · Visualizações: 136
cdd-pos055.jpg63.2 KB · Visualizações: 136 -
 cdd-pos056.jpg110.1 KB · Visualizações: 126
cdd-pos056.jpg110.1 KB · Visualizações: 126 -
 cdd-pos057.jpg82.1 KB · Visualizações: 123
cdd-pos057.jpg82.1 KB · Visualizações: 123 -
 cdd-pos058.jpg88.8 KB · Visualizações: 121
cdd-pos058.jpg88.8 KB · Visualizações: 121 -
 cdd-pos059.jpg69.2 KB · Visualizações: 128
cdd-pos059.jpg69.2 KB · Visualizações: 128 -
 cdd-pos060.jpg56.1 KB · Visualizações: 128
cdd-pos060.jpg56.1 KB · Visualizações: 128 -
 cdd-pos061.jpg65.3 KB · Visualizações: 123
cdd-pos061.jpg65.3 KB · Visualizações: 123 -
 cdd-pos062.jpg72.3 KB · Visualizações: 125
cdd-pos062.jpg72.3 KB · Visualizações: 125 -
 cdd-pos063.jpg62.7 KB · Visualizações: 123
cdd-pos063.jpg62.7 KB · Visualizações: 123 -
 cdd-pos064.jpg69.5 KB · Visualizações: 129
cdd-pos064.jpg69.5 KB · Visualizações: 129 -
 cdd-pos065.jpg69.2 KB · Visualizações: 134
cdd-pos065.jpg69.2 KB · Visualizações: 134 -
 cdd-pos066.jpg79.3 KB · Visualizações: 121
cdd-pos066.jpg79.3 KB · Visualizações: 121 -
 cdd-pos067.jpg89.7 KB · Visualizações: 133
cdd-pos067.jpg89.7 KB · Visualizações: 133 -
 cdd-pos068.jpg129 KB · Visualizações: 127
cdd-pos068.jpg129 KB · Visualizações: 127 -
 cdd-pos069.jpg112.1 KB · Visualizações: 127
cdd-pos069.jpg112.1 KB · Visualizações: 127 -
 cdd-pos070.jpg141.1 KB · Visualizações: 131
cdd-pos070.jpg141.1 KB · Visualizações: 131 -
 cdd-pos071.jpg60.5 KB · Visualizações: 119
cdd-pos071.jpg60.5 KB · Visualizações: 119 -
 cdd-pos072.jpg62 KB · Visualizações: 133
cdd-pos072.jpg62 KB · Visualizações: 133 -
 cdd-pos073.jpg37.2 KB · Visualizações: 125
cdd-pos073.jpg37.2 KB · Visualizações: 125 -
 cdd-pos074.jpg49.3 KB · Visualizações: 121
cdd-pos074.jpg49.3 KB · Visualizações: 121 -
 cdd-pos075.jpg62.1 KB · Visualizações: 125
cdd-pos075.jpg62.1 KB · Visualizações: 125 -
 cdd-pos076.jpg81.5 KB · Visualizações: 124
cdd-pos076.jpg81.5 KB · Visualizações: 124 -
 cdd-pos077.jpg73.3 KB · Visualizações: 127
cdd-pos077.jpg73.3 KB · Visualizações: 127 -
 cdd-pos078.jpg85.6 KB · Visualizações: 120
cdd-pos078.jpg85.6 KB · Visualizações: 120 -
 cdd-pos079.jpg92.7 KB · Visualizações: 132
cdd-pos079.jpg92.7 KB · Visualizações: 132 -
 cdd-pos080.jpg94.8 KB · Visualizações: 125
cdd-pos080.jpg94.8 KB · Visualizações: 125 -
 cdd-pos081.jpg84.6 KB · Visualizações: 130
cdd-pos081.jpg84.6 KB · Visualizações: 130 -
 cdd-pos082.jpg64.4 KB · Visualizações: 127
cdd-pos082.jpg64.4 KB · Visualizações: 127 -
 cdd-pos083.jpg64.9 KB · Visualizações: 125
cdd-pos083.jpg64.9 KB · Visualizações: 125 -
 cdd-pos084.jpg68.7 KB · Visualizações: 121
cdd-pos084.jpg68.7 KB · Visualizações: 121 -
 cdd-pos085.jpg79.8 KB · Visualizações: 122
cdd-pos085.jpg79.8 KB · Visualizações: 122 -
 cdd-pos086.jpg66.3 KB · Visualizações: 121
cdd-pos086.jpg66.3 KB · Visualizações: 121 -
 cdd-pos087.jpg70.5 KB · Visualizações: 123
cdd-pos087.jpg70.5 KB · Visualizações: 123 -
 cdd-pos088.jpg72.2 KB · Visualizações: 126
cdd-pos088.jpg72.2 KB · Visualizações: 126 -
 cdd-pos089.jpg63 KB · Visualizações: 127
cdd-pos089.jpg63 KB · Visualizações: 127 -
 cdd-pos090.jpg78.1 KB · Visualizações: 126
cdd-pos090.jpg78.1 KB · Visualizações: 126 -
 cdd-pos091.jpg60.8 KB · Visualizações: 119
cdd-pos091.jpg60.8 KB · Visualizações: 119 -
 cdd-pos092.jpg97.6 KB · Visualizações: 135
cdd-pos092.jpg97.6 KB · Visualizações: 135 -
 cdd-pos093.jpg45.2 KB · Visualizações: 127
cdd-pos093.jpg45.2 KB · Visualizações: 127 -
 cdd-pos094.jpg59.8 KB · Visualizações: 125
cdd-pos094.jpg59.8 KB · Visualizações: 125 -
 cdd-pos095.jpg92.3 KB · Visualizações: 123
cdd-pos095.jpg92.3 KB · Visualizações: 123 -
 cdd-pos096.jpg40.8 KB · Visualizações: 124
cdd-pos096.jpg40.8 KB · Visualizações: 124 -
 cdd-pos097.jpg74.7 KB · Visualizações: 137
cdd-pos097.jpg74.7 KB · Visualizações: 137 -
 cdd-pos098.jpg88.9 KB · Visualizações: 129
cdd-pos098.jpg88.9 KB · Visualizações: 129 -
 cdd-pos099.jpg74.6 KB · Visualizações: 124
cdd-pos099.jpg74.6 KB · Visualizações: 124 -
 cdd-pos100.jpg77.1 KB · Visualizações: 130
cdd-pos100.jpg77.1 KB · Visualizações: 130 -
 cdd-pos101.jpg103.9 KB · Visualizações: 122
cdd-pos101.jpg103.9 KB · Visualizações: 122 -
 cdd-pos102.jpg110.5 KB · Visualizações: 125
cdd-pos102.jpg110.5 KB · Visualizações: 125 -
 cdd-pos103.jpg56.6 KB · Visualizações: 129
cdd-pos103.jpg56.6 KB · Visualizações: 129 -
 cdd-pos104.jpg73.5 KB · Visualizações: 121
cdd-pos104.jpg73.5 KB · Visualizações: 121 -
 cdd-pos105.jpg72.2 KB · Visualizações: 118
cdd-pos105.jpg72.2 KB · Visualizações: 118 -
 cdd-pos106.jpg93.4 KB · Visualizações: 125
cdd-pos106.jpg93.4 KB · Visualizações: 125 -
 cdd-pos107.jpg93.9 KB · Visualizações: 122
cdd-pos107.jpg93.9 KB · Visualizações: 122 -
 cdd-pos108.jpg102.9 KB · Visualizações: 125
cdd-pos108.jpg102.9 KB · Visualizações: 125 -
 cdd-pos109.jpg192.3 KB · Visualizações: 119
cdd-pos109.jpg192.3 KB · Visualizações: 119 -
 cdd-pos110.jpg177.6 KB · Visualizações: 120
cdd-pos110.jpg177.6 KB · Visualizações: 120 -
 cdd-pos111.jpg124.1 KB · Visualizações: 125
cdd-pos111.jpg124.1 KB · Visualizações: 125 -
 cdd-pos112.jpg113.6 KB · Visualizações: 128
cdd-pos112.jpg113.6 KB · Visualizações: 128 -
 cdd-pos113.jpg123 KB · Visualizações: 135
cdd-pos113.jpg123 KB · Visualizações: 135 -
 cdd-pos114.jpg121.4 KB · Visualizações: 122
cdd-pos114.jpg121.4 KB · Visualizações: 122 -
 cdd-pos115.jpg105.1 KB · Visualizações: 120
cdd-pos115.jpg105.1 KB · Visualizações: 120 -
 cdd-pos116.jpg75.4 KB · Visualizações: 126
cdd-pos116.jpg75.4 KB · Visualizações: 126 -
 cdd-pos117.jpg156.4 KB · Visualizações: 119
cdd-pos117.jpg156.4 KB · Visualizações: 119 -
 cdd-pos118.jpg149.1 KB · Visualizações: 127
cdd-pos118.jpg149.1 KB · Visualizações: 127 -
 cdd-pos119.jpg117.2 KB · Visualizações: 129
cdd-pos119.jpg117.2 KB · Visualizações: 129 -
 cdd-pos120.jpg130.6 KB · Visualizações: 125
cdd-pos120.jpg130.6 KB · Visualizações: 125 -
 cdd-pos121.jpg134.4 KB · Visualizações: 122
cdd-pos121.jpg134.4 KB · Visualizações: 122 -
 cdd-pos122.jpg107.4 KB · Visualizações: 126
cdd-pos122.jpg107.4 KB · Visualizações: 126 -
 cdd-pos123.jpg105.7 KB · Visualizações: 130
cdd-pos123.jpg105.7 KB · Visualizações: 130 -
 cdd-pos124.jpg177.4 KB · Visualizações: 123
cdd-pos124.jpg177.4 KB · Visualizações: 123 -
 cdd-pos125.jpg47.3 KB · Visualizações: 126
cdd-pos125.jpg47.3 KB · Visualizações: 126 -
 cdd-pos126.jpg46.3 KB · Visualizações: 122
cdd-pos126.jpg46.3 KB · Visualizações: 122 -
 cdd-pos127.jpg52.1 KB · Visualizações: 128
cdd-pos127.jpg52.1 KB · Visualizações: 128 -
 cdd-pos128.jpg54.8 KB · Visualizações: 119
cdd-pos128.jpg54.8 KB · Visualizações: 119 -
 cdd-pos129.jpg107 KB · Visualizações: 130
cdd-pos129.jpg107 KB · Visualizações: 130 -
 cdd-pos130.jpg104.5 KB · Visualizações: 126
cdd-pos130.jpg104.5 KB · Visualizações: 126 -
 cdd-pos131.jpg83.1 KB · Visualizações: 125
cdd-pos131.jpg83.1 KB · Visualizações: 125 -
 cdd-pos132.jpg47.3 KB · Visualizações: 125
cdd-pos132.jpg47.3 KB · Visualizações: 125 -
 cdd-pos133.jpg79.5 KB · Visualizações: 128
cdd-pos133.jpg79.5 KB · Visualizações: 128 -
 cdd-pos134.jpg123.9 KB · Visualizações: 129
cdd-pos134.jpg123.9 KB · Visualizações: 129 -
 cdd-pos135.jpg94.3 KB · Visualizações: 128
cdd-pos135.jpg94.3 KB · Visualizações: 128 -
 cdd-pos136.jpg81 KB · Visualizações: 126
cdd-pos136.jpg81 KB · Visualizações: 126 -
 cdd-pos137.jpg55.4 KB · Visualizações: 129
cdd-pos137.jpg55.4 KB · Visualizações: 129 -
 cdd-pos138.jpg58.2 KB · Visualizações: 121
cdd-pos138.jpg58.2 KB · Visualizações: 121 -
 cdd-pos139.jpg109 KB · Visualizações: 132
cdd-pos139.jpg109 KB · Visualizações: 132 -
 cdd-pos140.jpg97.2 KB · Visualizações: 131
cdd-pos140.jpg97.2 KB · Visualizações: 131 -
 cdd-pos141.jpg113.9 KB · Visualizações: 125
cdd-pos141.jpg113.9 KB · Visualizações: 125 -
 cdd-pos142.jpg79.2 KB · Visualizações: 116
cdd-pos142.jpg79.2 KB · Visualizações: 116 -
 cdd-pos143.jpg70.7 KB · Visualizações: 121
cdd-pos143.jpg70.7 KB · Visualizações: 121 -
 cdd-pos144.jpg70 KB · Visualizações: 123
cdd-pos144.jpg70 KB · Visualizações: 123 -
 cdd-pos145.jpg61.9 KB · Visualizações: 124
cdd-pos145.jpg61.9 KB · Visualizações: 124 -
 cdd-pos146.jpg95 KB · Visualizações: 124
cdd-pos146.jpg95 KB · Visualizações: 124 -
 cdd-pos147.jpg110.8 KB · Visualizações: 122
cdd-pos147.jpg110.8 KB · Visualizações: 122 -
 cdd-pos148.jpg106.5 KB · Visualizações: 118
cdd-pos148.jpg106.5 KB · Visualizações: 118 -
 cdd-pos149.jpg75.2 KB · Visualizações: 122
cdd-pos149.jpg75.2 KB · Visualizações: 122 -
 cdd-pos150.jpg46.1 KB · Visualizações: 120
cdd-pos150.jpg46.1 KB · Visualizações: 120 -
 cdd-pos151.jpg94.7 KB · Visualizações: 122
cdd-pos151.jpg94.7 KB · Visualizações: 122 -
 cdd-pos152.jpg58.3 KB · Visualizações: 124
cdd-pos152.jpg58.3 KB · Visualizações: 124 -
 cdd-pos153.jpg54.6 KB · Visualizações: 124
cdd-pos153.jpg54.6 KB · Visualizações: 124 -
 cdd-pos154.jpg52.6 KB · Visualizações: 126
cdd-pos154.jpg52.6 KB · Visualizações: 126 -
 cdd-pos155.jpg95.7 KB · Visualizações: 123
cdd-pos155.jpg95.7 KB · Visualizações: 123 -
 cdd-pos156.jpg63.9 KB · Visualizações: 126
cdd-pos156.jpg63.9 KB · Visualizações: 126 -
 cdd-pos157.jpg75.4 KB · Visualizações: 131
cdd-pos157.jpg75.4 KB · Visualizações: 131 -
 cdd-pos158.jpg93.8 KB · Visualizações: 129
cdd-pos158.jpg93.8 KB · Visualizações: 129 -
 cdd-pos159.jpg124.6 KB · Visualizações: 115
cdd-pos159.jpg124.6 KB · Visualizações: 115 -
 cdd-pos160.jpg94.3 KB · Visualizações: 119
cdd-pos160.jpg94.3 KB · Visualizações: 119 -
 cdd-pos161.jpg134.8 KB · Visualizações: 125
cdd-pos161.jpg134.8 KB · Visualizações: 125 -
 cdd-pos162.jpg135 KB · Visualizações: 122
cdd-pos162.jpg135 KB · Visualizações: 122 -
 cdd-pos163.jpg84.2 KB · Visualizações: 123
cdd-pos163.jpg84.2 KB · Visualizações: 123 -
 cdd-pos164.jpg79.4 KB · Visualizações: 119
cdd-pos164.jpg79.4 KB · Visualizações: 119 -
 cdd-pos165.jpg91.9 KB · Visualizações: 122
cdd-pos165.jpg91.9 KB · Visualizações: 122 -
 cdd-pos166.jpg56.1 KB · Visualizações: 120
cdd-pos166.jpg56.1 KB · Visualizações: 120 -
 cdd-pos167.jpg89.1 KB · Visualizações: 121
cdd-pos167.jpg89.1 KB · Visualizações: 121 -
 cdd-pos168.jpg84.9 KB · Visualizações: 121
cdd-pos168.jpg84.9 KB · Visualizações: 121 -
 cdd-pos169.jpg67 KB · Visualizações: 119
cdd-pos169.jpg67 KB · Visualizações: 119 -
 cdd-pos170.jpg85.9 KB · Visualizações: 124
cdd-pos170.jpg85.9 KB · Visualizações: 124 -
 cdd-pos171.jpg66.9 KB · Visualizações: 113
cdd-pos171.jpg66.9 KB · Visualizações: 113 -
 cdd-pos172.jpg75.1 KB · Visualizações: 114
cdd-pos172.jpg75.1 KB · Visualizações: 114 -
 cdd-pos173.jpg78.6 KB · Visualizações: 120
cdd-pos173.jpg78.6 KB · Visualizações: 120 -
 cdd-pos174.jpg66.5 KB · Visualizações: 120
cdd-pos174.jpg66.5 KB · Visualizações: 120 -
 cdd-pos175.jpg73.3 KB · Visualizações: 119
cdd-pos175.jpg73.3 KB · Visualizações: 119 -
 cdd-pos176.jpg77.4 KB · Visualizações: 121
cdd-pos176.jpg77.4 KB · Visualizações: 121 -
 cdd-pos177.jpg91.4 KB · Visualizações: 123
cdd-pos177.jpg91.4 KB · Visualizações: 123 -
 cdd-pos178.jpg76.6 KB · Visualizações: 122
cdd-pos178.jpg76.6 KB · Visualizações: 122 -
 cdd-pos179.jpg89.9 KB · Visualizações: 120
cdd-pos179.jpg89.9 KB · Visualizações: 120 -
 cdd-pos180.jpg64.9 KB · Visualizações: 117
cdd-pos180.jpg64.9 KB · Visualizações: 117 -
 cdd-pos181.jpg86.5 KB · Visualizações: 127
cdd-pos181.jpg86.5 KB · Visualizações: 127 -
 cdd-pos182.jpg63.7 KB · Visualizações: 117
cdd-pos182.jpg63.7 KB · Visualizações: 117 -
 cdd-pos183.jpg59.5 KB · Visualizações: 120
cdd-pos183.jpg59.5 KB · Visualizações: 120 -
 cdd-pos184.jpg102.5 KB · Visualizações: 121
cdd-pos184.jpg102.5 KB · Visualizações: 121 -
 cdd-pos185.jpg90.5 KB · Visualizações: 130
cdd-pos185.jpg90.5 KB · Visualizações: 130 -
 cdd-pos186.jpg97.2 KB · Visualizações: 116
cdd-pos186.jpg97.2 KB · Visualizações: 116 -
 cdd-pos187.jpg103.3 KB · Visualizações: 125
cdd-pos187.jpg103.3 KB · Visualizações: 125 -
 cdd-pos188.jpg69 KB · Visualizações: 127
cdd-pos188.jpg69 KB · Visualizações: 127 -
 cdd-pos189.jpg70.9 KB · Visualizações: 117
cdd-pos189.jpg70.9 KB · Visualizações: 117 -
 cdd-pos190.jpg75.6 KB · Visualizações: 122
cdd-pos190.jpg75.6 KB · Visualizações: 122 -
 cdd-pos191.jpg108.9 KB · Visualizações: 117
cdd-pos191.jpg108.9 KB · Visualizações: 117 -
 cdd-pos192.jpg59.2 KB · Visualizações: 123
cdd-pos192.jpg59.2 KB · Visualizações: 123 -
 cdd-pos193.jpg54 KB · Visualizações: 116
cdd-pos193.jpg54 KB · Visualizações: 116 -
 cdd-pos194.jpg57.7 KB · Visualizações: 118
cdd-pos194.jpg57.7 KB · Visualizações: 118 -
 cdd-pos195.jpg62.2 KB · Visualizações: 114
cdd-pos195.jpg62.2 KB · Visualizações: 114 -
 cdd-pos196.jpg76.7 KB · Visualizações: 124
cdd-pos196.jpg76.7 KB · Visualizações: 124 -
 cdd-pos197.jpg125.6 KB · Visualizações: 128
cdd-pos197.jpg125.6 KB · Visualizações: 128 -
 cdd-pos198.jpg73.5 KB · Visualizações: 119
cdd-pos198.jpg73.5 KB · Visualizações: 119 -
 cdd-pos199.jpg85.8 KB · Visualizações: 119
cdd-pos199.jpg85.8 KB · Visualizações: 119 -
 cdd-pos200.jpg83.1 KB · Visualizações: 118
cdd-pos200.jpg83.1 KB · Visualizações: 118 -
 cdd-pos201.jpg74 KB · Visualizações: 126
cdd-pos201.jpg74 KB · Visualizações: 126 -
 cdd-pos202.jpg83.1 KB · Visualizações: 126
cdd-pos202.jpg83.1 KB · Visualizações: 126 -
 cdd-pos203.jpg45.1 KB · Visualizações: 124
cdd-pos203.jpg45.1 KB · Visualizações: 124 -
 cdd-pos204.jpg96.8 KB · Visualizações: 124
cdd-pos204.jpg96.8 KB · Visualizações: 124 -
 cdd-pos205.jpg114.3 KB · Visualizações: 120
cdd-pos205.jpg114.3 KB · Visualizações: 120 -
 cdd-pos206.jpg68.1 KB · Visualizações: 120
cdd-pos206.jpg68.1 KB · Visualizações: 120 -
 cdd-pos207.jpg77.7 KB · Visualizações: 128
cdd-pos207.jpg77.7 KB · Visualizações: 128 -
 cdd-pos208.jpg44.7 KB · Visualizações: 121
cdd-pos208.jpg44.7 KB · Visualizações: 121 -
cdd-pos209.jpg44.5 KB · Visualizações: 121
cdd-pos209.jpg44.5 KB · Visualizações: 121 -
 cdd-pos210.jpg70.1 KB · Visualizações: 118
cdd-pos210.jpg70.1 KB · Visualizações: 118 -
 cdd-pos211.jpg51.5 KB · Visualizações: 114
cdd-pos211.jpg51.5 KB · Visualizações: 114 -
 cdd-pos212.jpg74 KB · Visualizações: 122
cdd-pos212.jpg74 KB · Visualizações: 122 -
 cdd-pos213.jpg95.7 KB · Visualizações: 120
cdd-pos213.jpg95.7 KB · Visualizações: 120 -
 cdd-pos214.jpg115.4 KB · Visualizações: 123
cdd-pos214.jpg115.4 KB · Visualizações: 123 -
 cdd-pos215.jpg121.2 KB · Visualizações: 124
cdd-pos215.jpg121.2 KB · Visualizações: 124 -
 cdd-pos216.jpg173 KB · Visualizações: 124
cdd-pos216.jpg173 KB · Visualizações: 124 -
 cdd-pos217.jpg78.5 KB · Visualizações: 120
cdd-pos217.jpg78.5 KB · Visualizações: 120 -
 cdd-pos218.jpg88 KB · Visualizações: 119
cdd-pos218.jpg88 KB · Visualizações: 119 -
 cdd-pos219.jpg87.1 KB · Visualizações: 119
cdd-pos219.jpg87.1 KB · Visualizações: 119 -
 cdd-pos220.jpg186.5 KB · Visualizações: 122
cdd-pos220.jpg186.5 KB · Visualizações: 122 -
 cdd-pos221.jpg80.2 KB · Visualizações: 122
cdd-pos221.jpg80.2 KB · Visualizações: 122 -
 cdd-pos222.jpg83.7 KB · Visualizações: 120
cdd-pos222.jpg83.7 KB · Visualizações: 120 -
 cdd-pos223.jpg104.8 KB · Visualizações: 122
cdd-pos223.jpg104.8 KB · Visualizações: 122 -
 cdd-pos224.jpg86.7 KB · Visualizações: 118
cdd-pos224.jpg86.7 KB · Visualizações: 118 -
 cdd-pos225.jpg73.5 KB · Visualizações: 699
cdd-pos225.jpg73.5 KB · Visualizações: 699 -
 cdd-pos226.jpg84.2 KB · Visualizações: 118
cdd-pos226.jpg84.2 KB · Visualizações: 118 -
 cdd-pos227.jpg41.5 KB · Visualizações: 119
cdd-pos227.jpg41.5 KB · Visualizações: 119 -
 cdd-pos228.jpg119 KB · Visualizações: 117
cdd-pos228.jpg119 KB · Visualizações: 117 -
 cdd-pos229.jpg90.6 KB · Visualizações: 117
cdd-pos229.jpg90.6 KB · Visualizações: 117 -
 cdd-pos230.jpg54.5 KB · Visualizações: 121
cdd-pos230.jpg54.5 KB · Visualizações: 121 -
 cdd-pos231.jpg74.5 KB · Visualizações: 123
cdd-pos231.jpg74.5 KB · Visualizações: 123 -
 cdd-pos232.jpg81.2 KB · Visualizações: 132
cdd-pos232.jpg81.2 KB · Visualizações: 132 -
 cdd-pos233.jpg79.8 KB · Visualizações: 133
cdd-pos233.jpg79.8 KB · Visualizações: 133 -
 cdd-pos234.jpg56.9 KB · Visualizações: 119
cdd-pos234.jpg56.9 KB · Visualizações: 119 -
 cdd-pos235.jpg68.3 KB · Visualizações: 121
cdd-pos235.jpg68.3 KB · Visualizações: 121 -
 cdd-pos236.jpg91.5 KB · Visualizações: 112
cdd-pos236.jpg91.5 KB · Visualizações: 112 -
 cdd-pos237.jpg39.9 KB · Visualizações: 115
cdd-pos237.jpg39.9 KB · Visualizações: 115 -
 cdd-pos238.jpg82.4 KB · Visualizações: 117
cdd-pos238.jpg82.4 KB · Visualizações: 117 -
 cdd-pos239.jpg83.6 KB · Visualizações: 121
cdd-pos239.jpg83.6 KB · Visualizações: 121 -
 cdd-pos240.jpg118.3 KB · Visualizações: 116
cdd-pos240.jpg118.3 KB · Visualizações: 116 -
 cdd-pos241.jpg122.7 KB · Visualizações: 126
cdd-pos241.jpg122.7 KB · Visualizações: 126 -
 cdd-pos242.jpg192 KB · Visualizações: 125
cdd-pos242.jpg192 KB · Visualizações: 125 -
 cdd-pos243.jpg113.3 KB · Visualizações: 125
cdd-pos243.jpg113.3 KB · Visualizações: 125 -
 cdd-pos244.jpg131.8 KB · Visualizações: 117
cdd-pos244.jpg131.8 KB · Visualizações: 117 -
 cdd-pos245.jpg111.7 KB · Visualizações: 126
cdd-pos245.jpg111.7 KB · Visualizações: 126
Teonanacatl.org
Aqui discutimos micologia amadora e enteogenia.
Cadastre-se para virar um membro da comunidade! Após seu cadastro, você poderá participar deste site adicionando seus próprios tópicos e postagens.
-
Por favor, leia com atenção as Regras e o Termo de Responsabilidade do Fórum. Ambos lhe ajudarão a entender o que esperamos em termos de conduta no Fórum e também o posicionamento legal do mesmo.
Completo Pleurotus Ostreatus (Shimeji)
- Adicionado por cubensisdedread
- Create date
